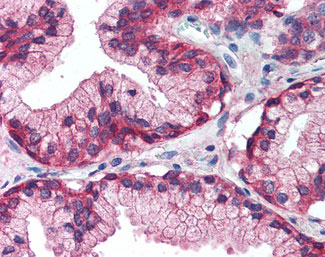

- SELECT id FROM application WHERE name = 'ELISA'
- ELISA [19] SELECT id FROM application WHERE name = 'FC'
- FC [1] SELECT id FROM application WHERE name = 'ICC'
- ICC [1] SELECT id FROM application WHERE name = 'ID'
- ID [2] SELECT id FROM application WHERE name = 'IE'
- IE [4] SELECT id FROM application WHERE name = 'IF'
- IF [2] SELECT id FROM application WHERE name = 'IHC'
- IHC [4] SELECT id FROM application WHERE name = 'IHC-Fr'
- IHC-Fr [2] SELECT id FROM application WHERE name = 'IHC-P'
- IHC-P [19] SELECT id FROM application WHERE name = 'IP'
- IP [5] SELECT id FROM application WHERE name = 'NT'
- NT [2] SELECT id FROM application WHERE name = 'WB'
- WB [9]
19 PRODUCTS
-
Catalogue Number: ALS11216-ABG
Category: antibody
Type: Polyclonal Primary Antibody - Unconjugated
Manufacturer Name: Abcepta
Description:
Application: ELISA IHC-P IHC-Fr
Unit(s): 50 ul
Datasheet ✔
-
Catalogue Number: ALS11218-ABG
Category: antibody
Type: Polyclonal Primary Antibody - Unconjugated
Manufacturer Name: Abcepta
Description:
Application: ELISA IHC-P
Unit(s): 50 ug
Datasheet ✔
-
Catalogue Number: ALS11757-ABG
Category: antibody
Type: Polyclonal Primary Antibody - Unconjugated
Manufacturer Name: Abcepta
Description:
Application: ELISA IF IHC-P IP WB IHC
Unit(s): 50 ul
Datasheet ✔
-
Catalogue Number: ALS12167-ABG
Category: antibody
Type: Polyclonal Primary Antibody - Unconjugated
Manufacturer Name: Abcepta
Description:
Application: ELISA ICC IF IHC-P IP WB
Unit(s): 50 ug
Datasheet ✔
-
Catalogue Number: ALS12466-ABG
Category: antibody
Type: Polyclonal Primary Antibody - Unconjugated
Manufacturer Name: Abcepta
Description:
Application: ELISA IHC-P
Unit(s): 50 ug
Datasheet ✔
-
Catalogue Number: ALS12590-ABG
Category: antibody
Type: Polyclonal Primary Antibody - Unconjugated
Manufacturer Name: Abcepta
Description:
Application: ELISA IHC-P IP NT
Unit(s): 250 ug
Datasheet ✔
-
Catalogue Number: ALS13259-ABG
Category: antibody
Type: Polyclonal Primary Antibody - Unconjugated
Manufacturer Name: Abcepta
Description:
Application: ELISA ID IE IHC-P IHC
Unit(s): 50 ug
Datasheet ✔
-
Catalogue Number: ALS13262-ABG
Category: antibody
Type: Polyclonal Primary Antibody - Unconjugated
Manufacturer Name: Abcepta
Description:
Application: ELISA IHC-P WB
Unit(s): 500 ug
Datasheet ✔
-
Catalogue Number: ALS13264-ABG
Category: antibody
Type: Polyclonal Primary Antibody - Unconjugated
Manufacturer Name: Abcepta
Description:
Application: ELISA IE IHC-P
Unit(s): 50 ug
Datasheet ✔
-
Catalogue Number: ALS14236-ABG
Category: antibody
Type: Polyclonal Primary Antibody - Unconjugated
Manufacturer Name: Abcepta
Application: ELISA IHC-P IHC-Fr
Unit(s): 50 ul
Datasheet ✔
- Page 1 of 2
- Next